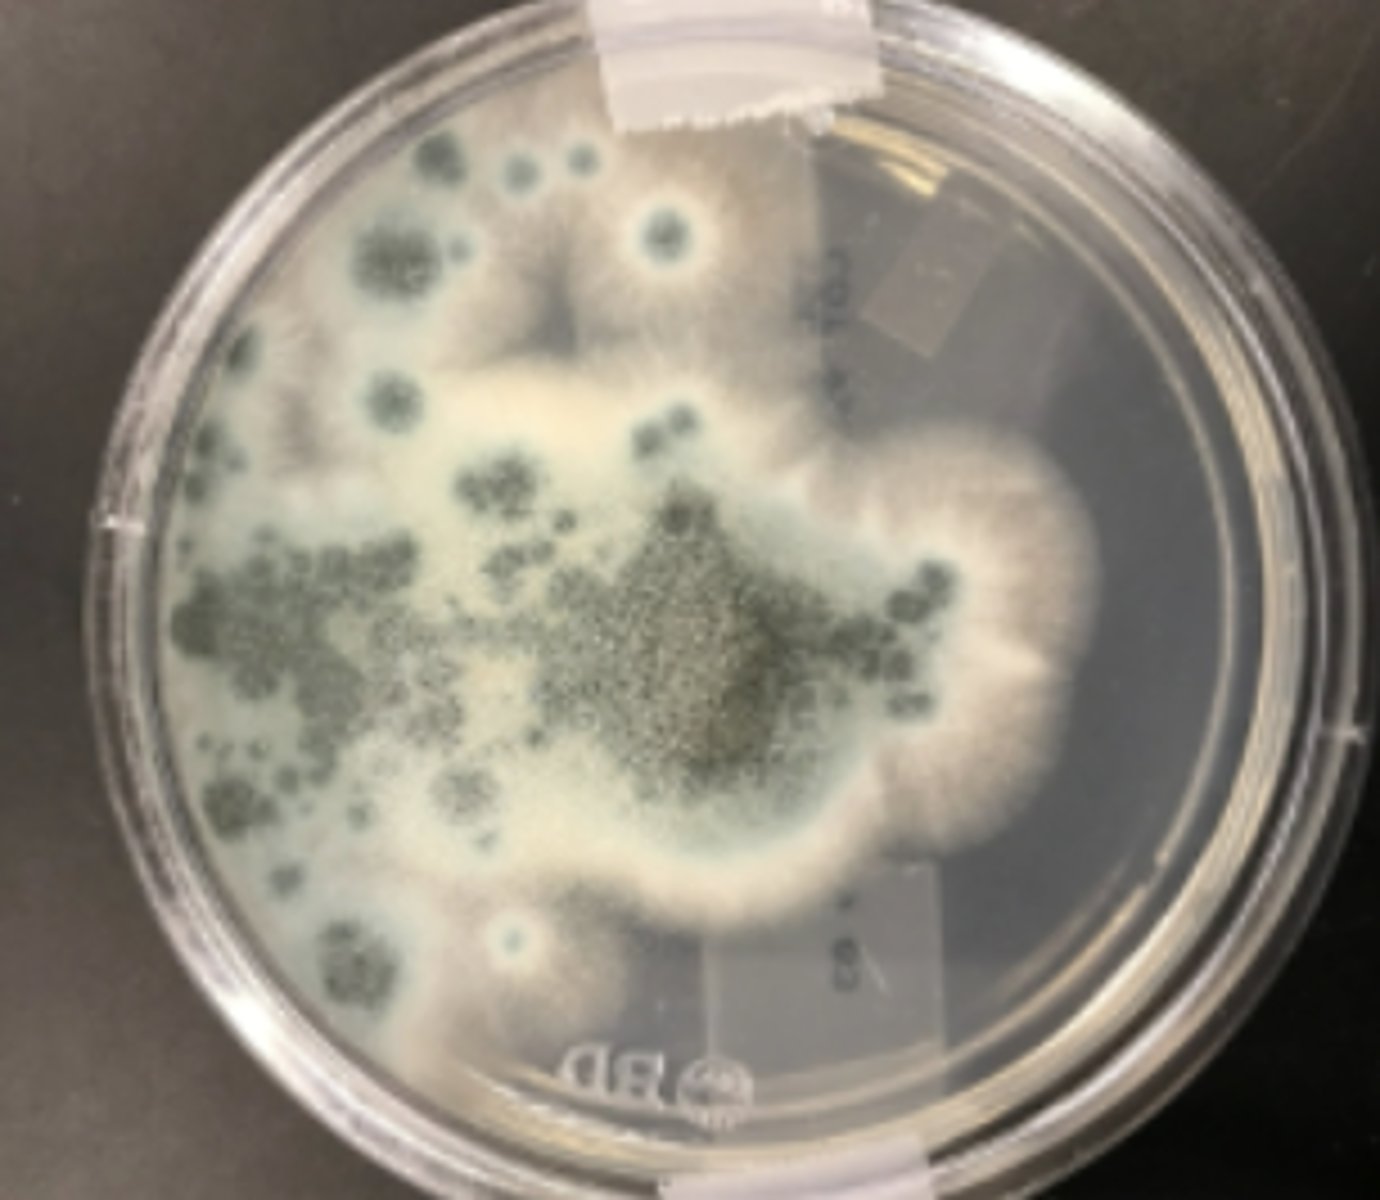
knowt flashcard image
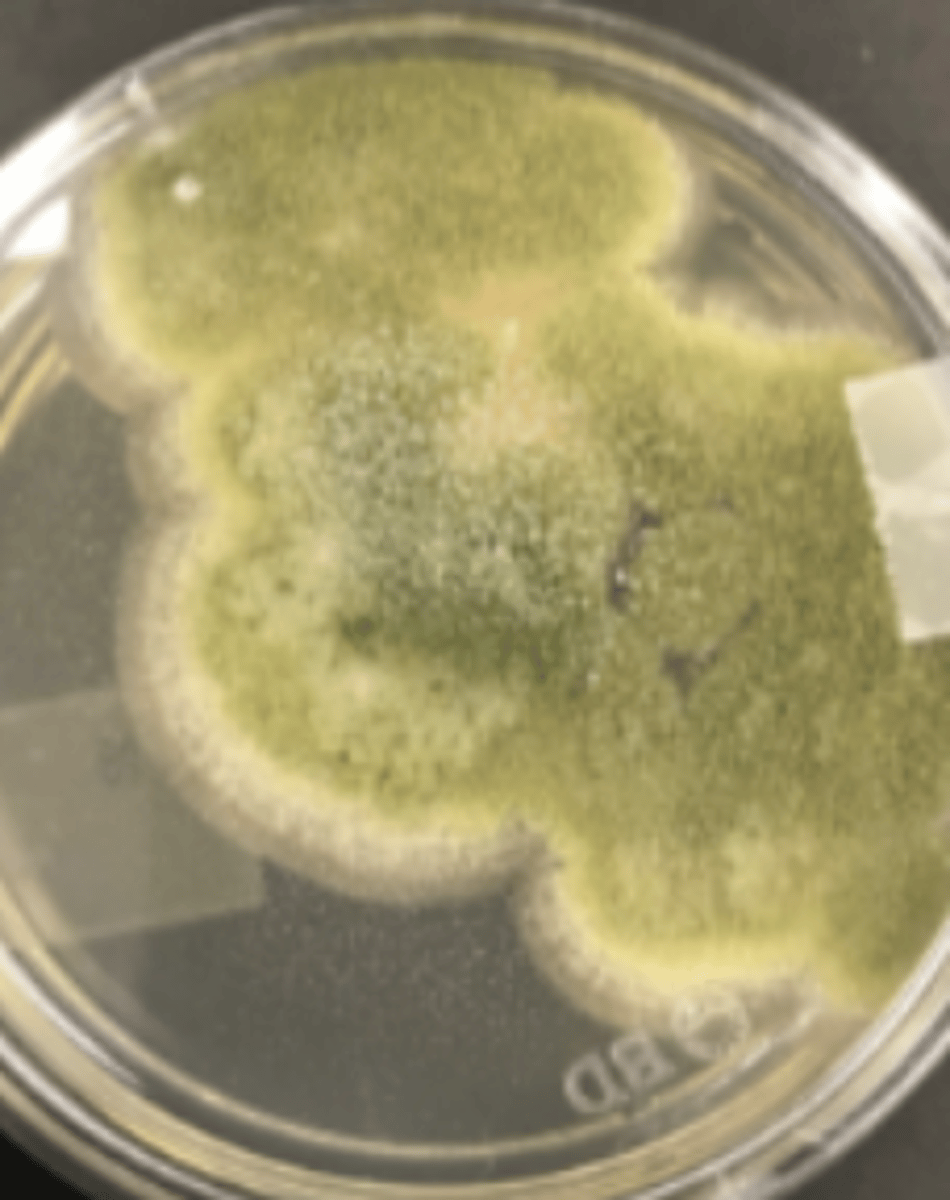
knowt flashcard image
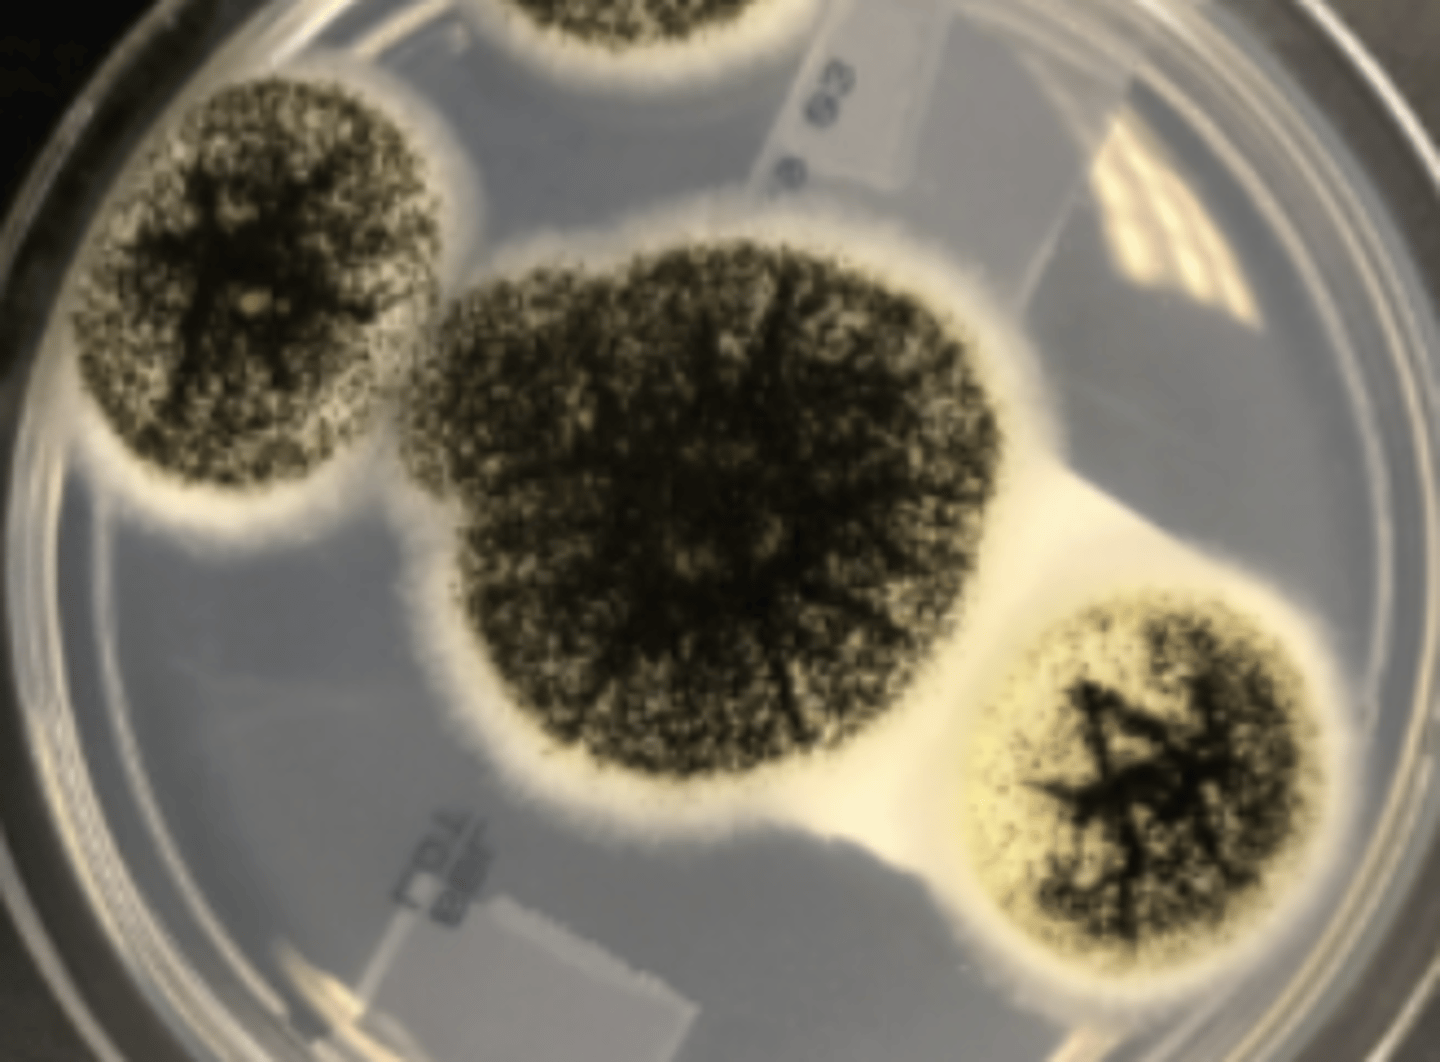
knowt flashcard image
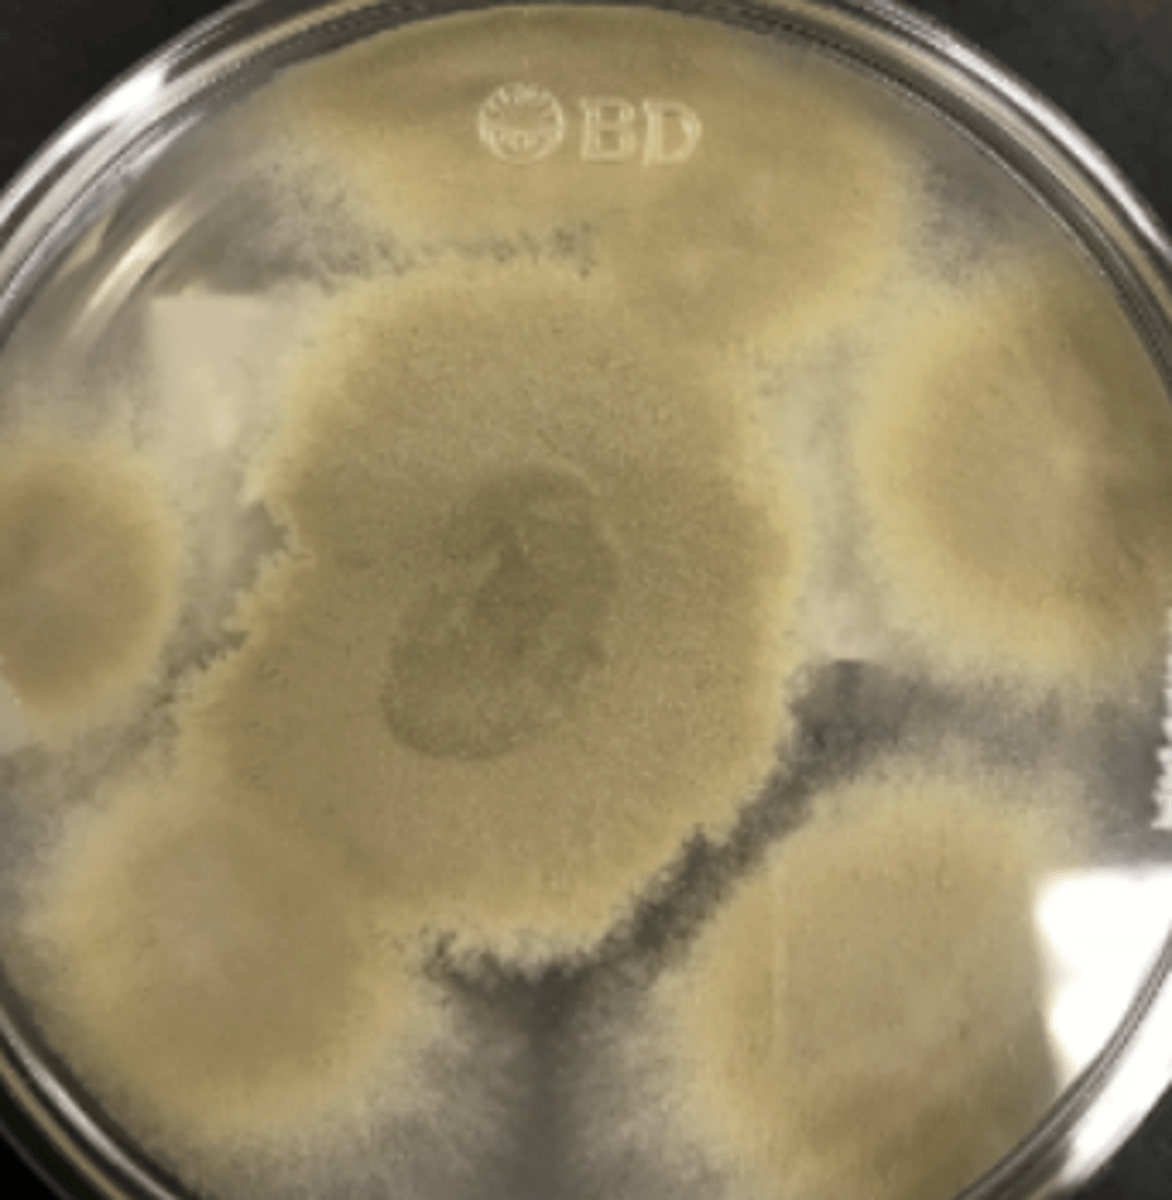
knowt flashcard image
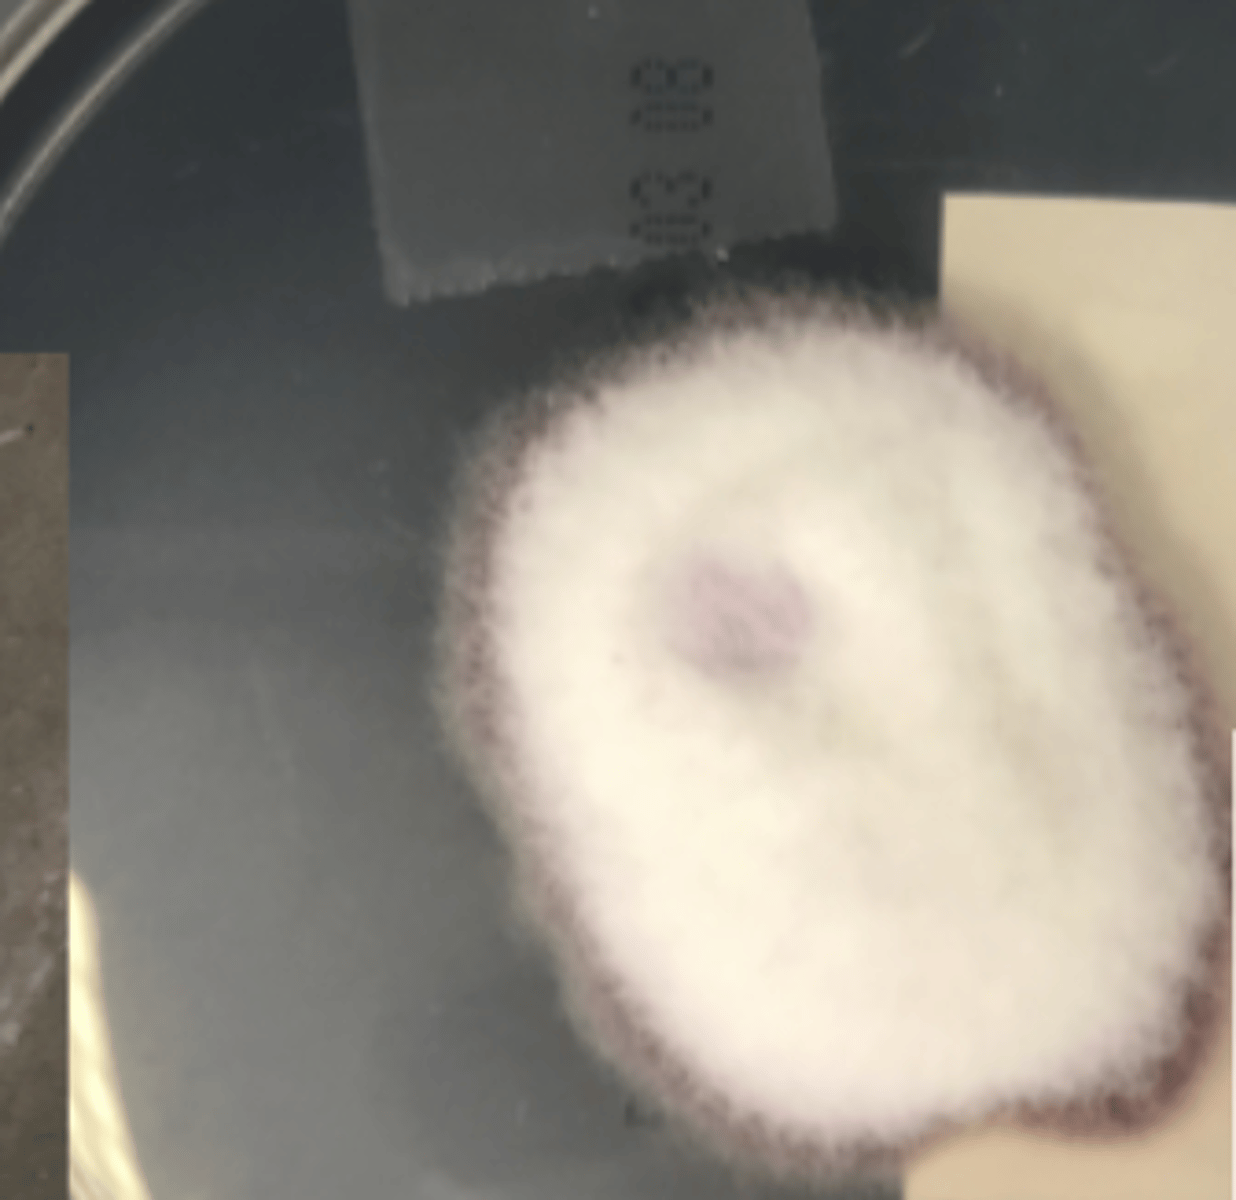
knowt flashcard image
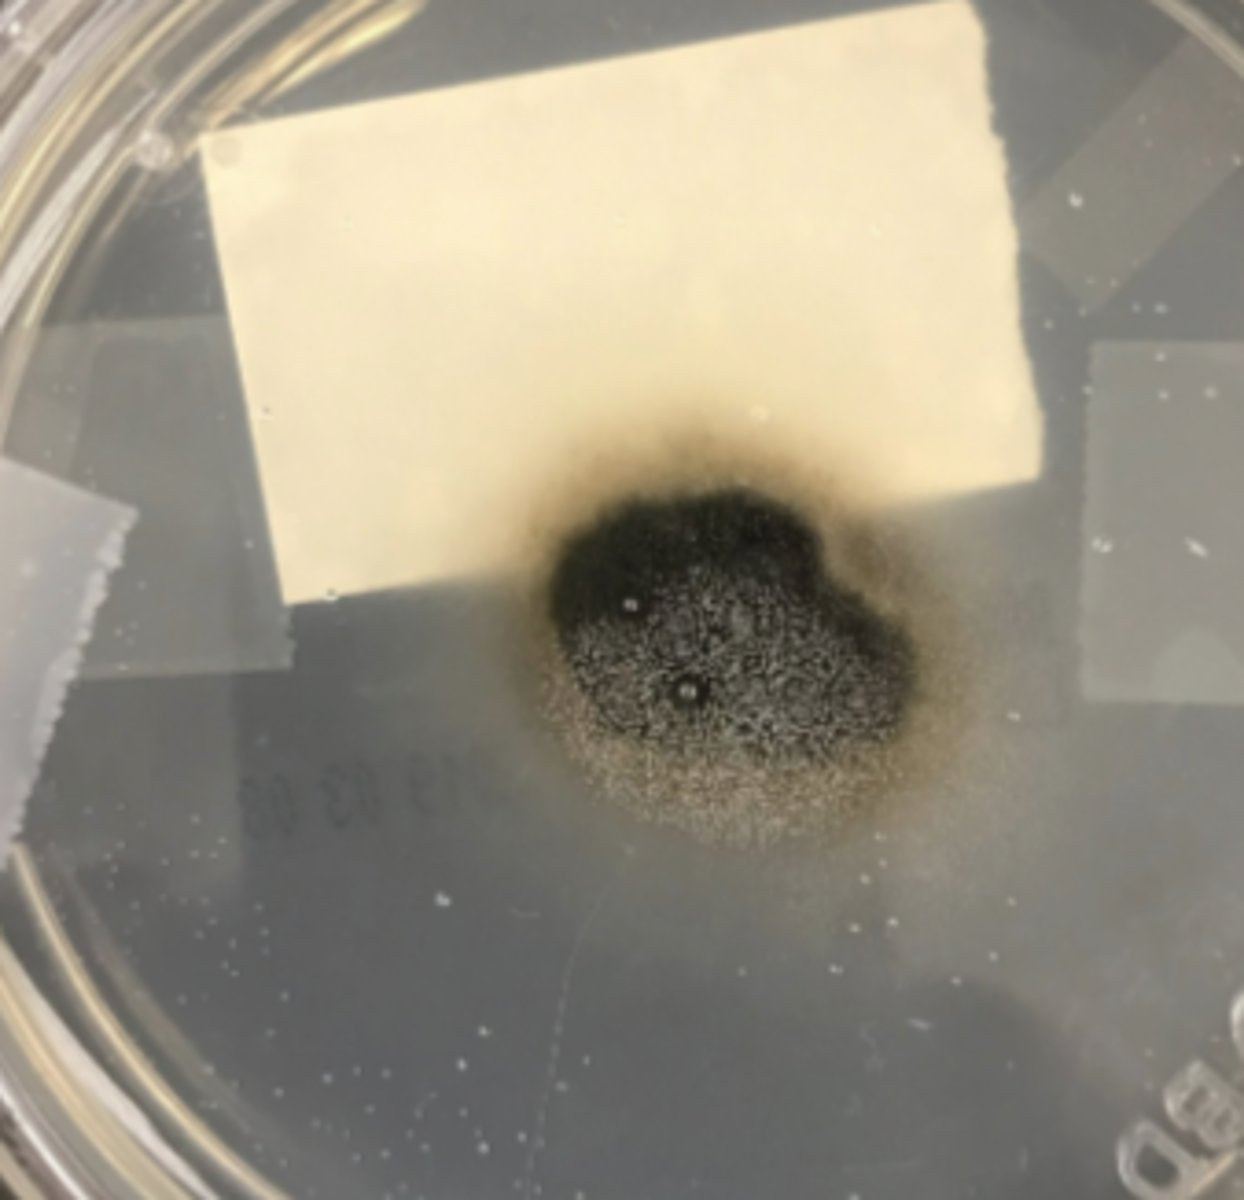
knowt flashcard image
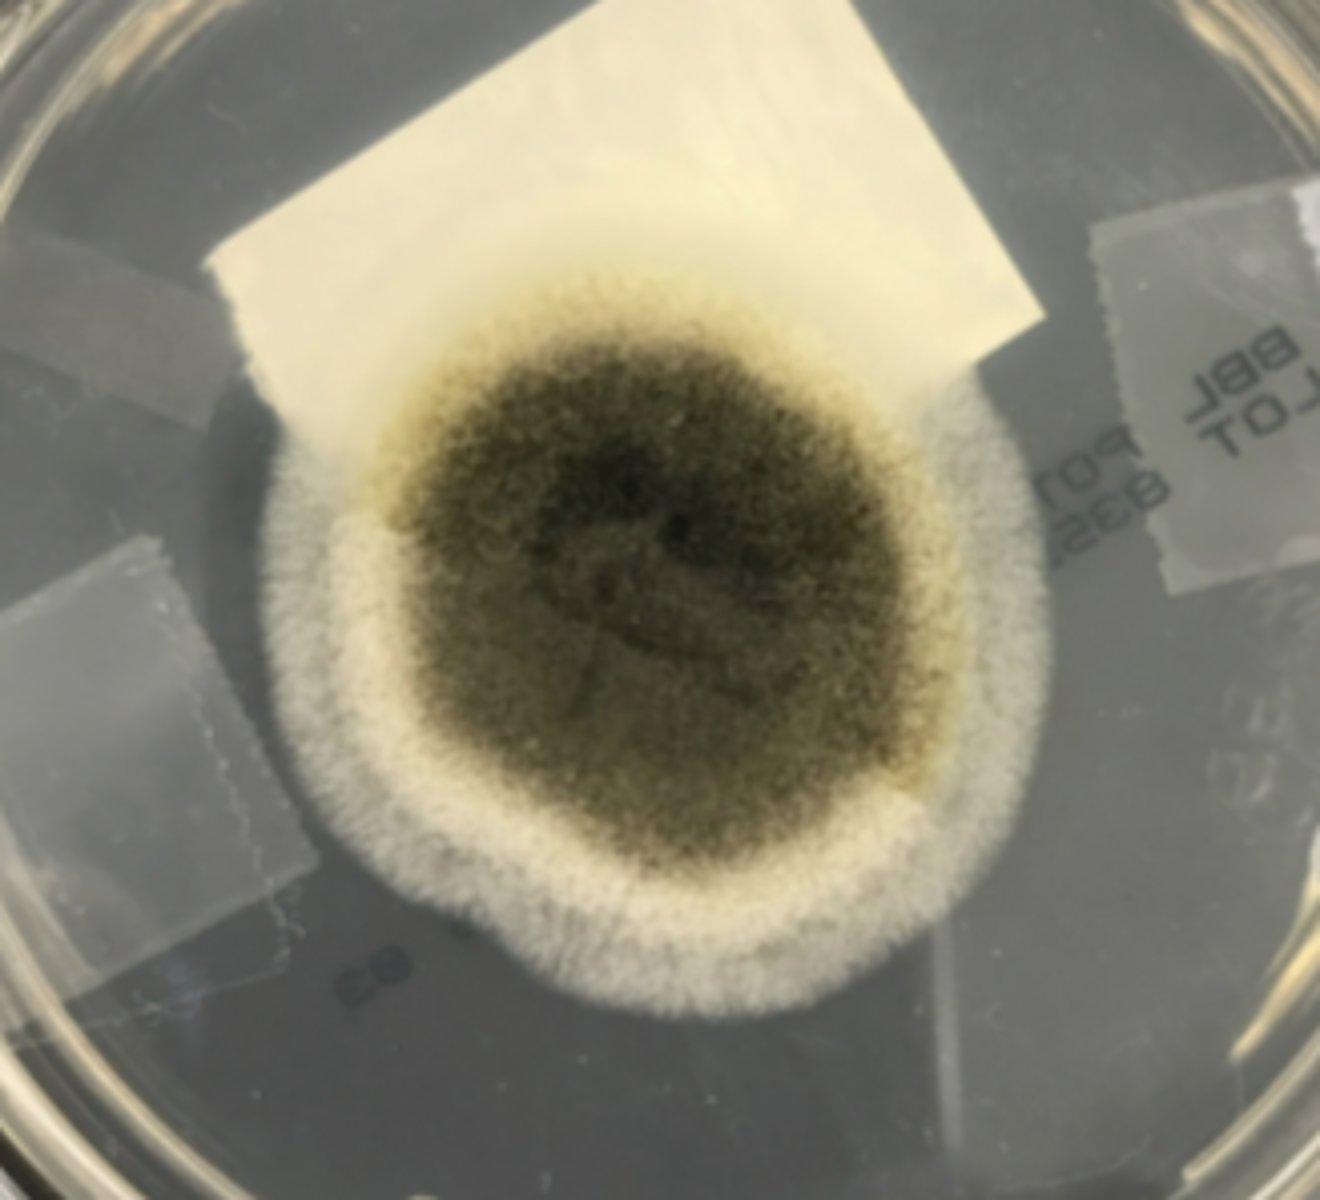
knowt flashcard image
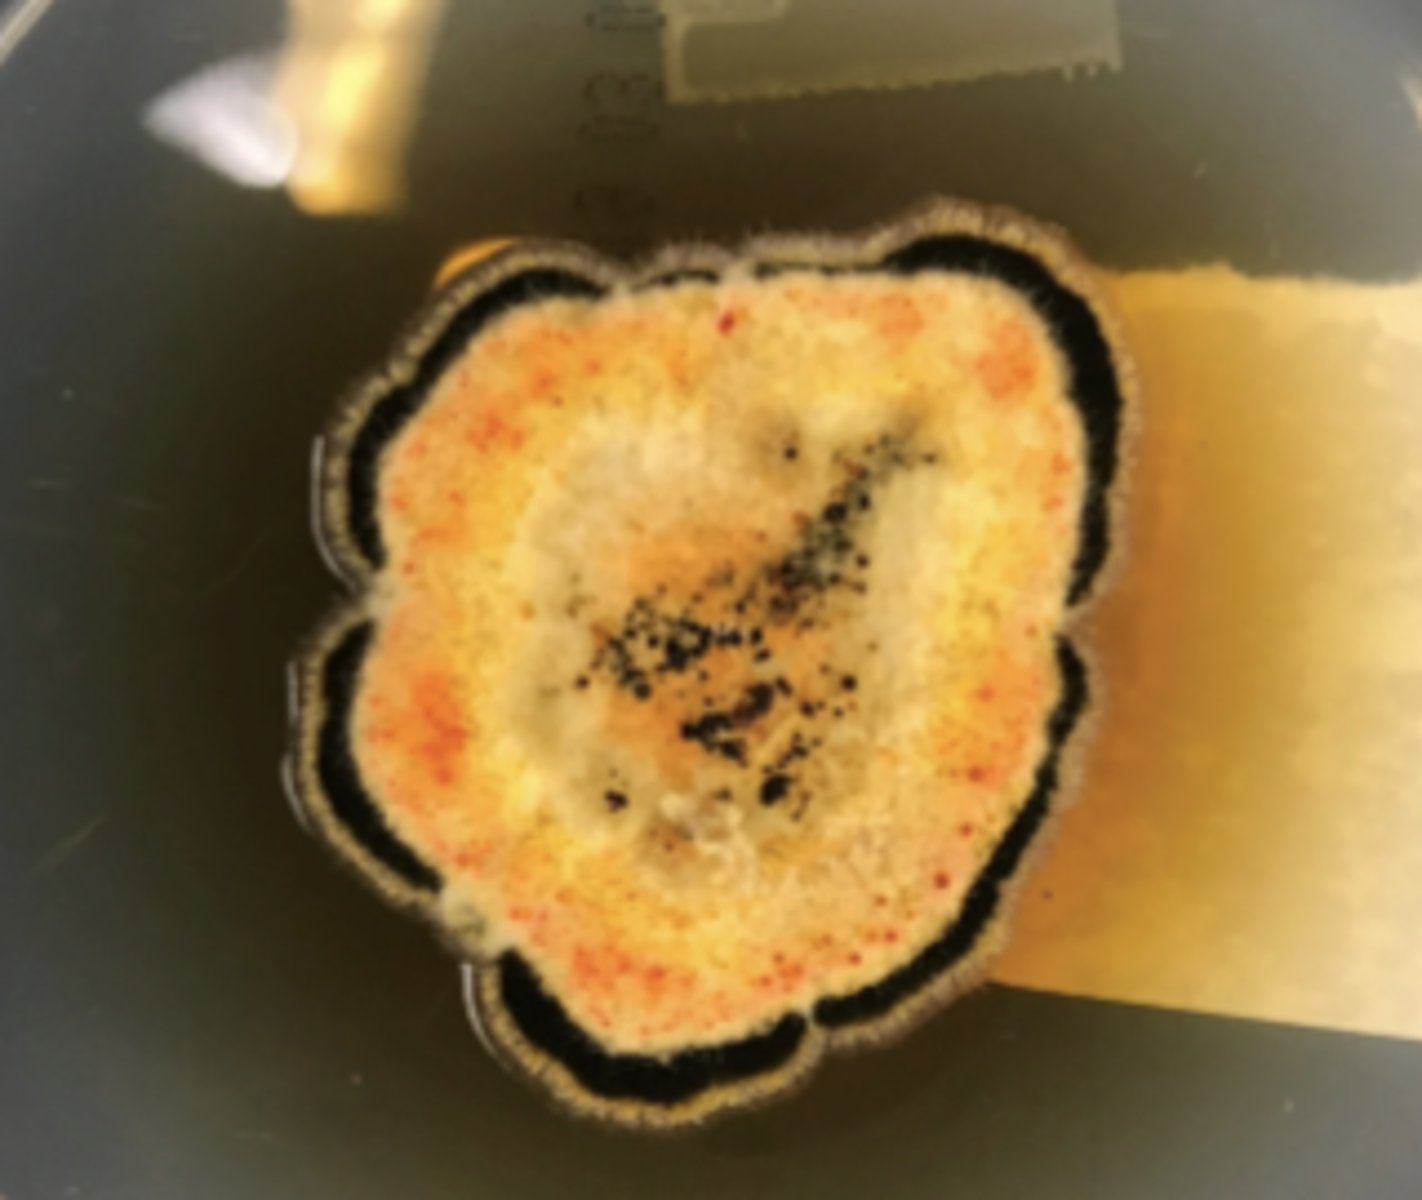
knowt flashcard image
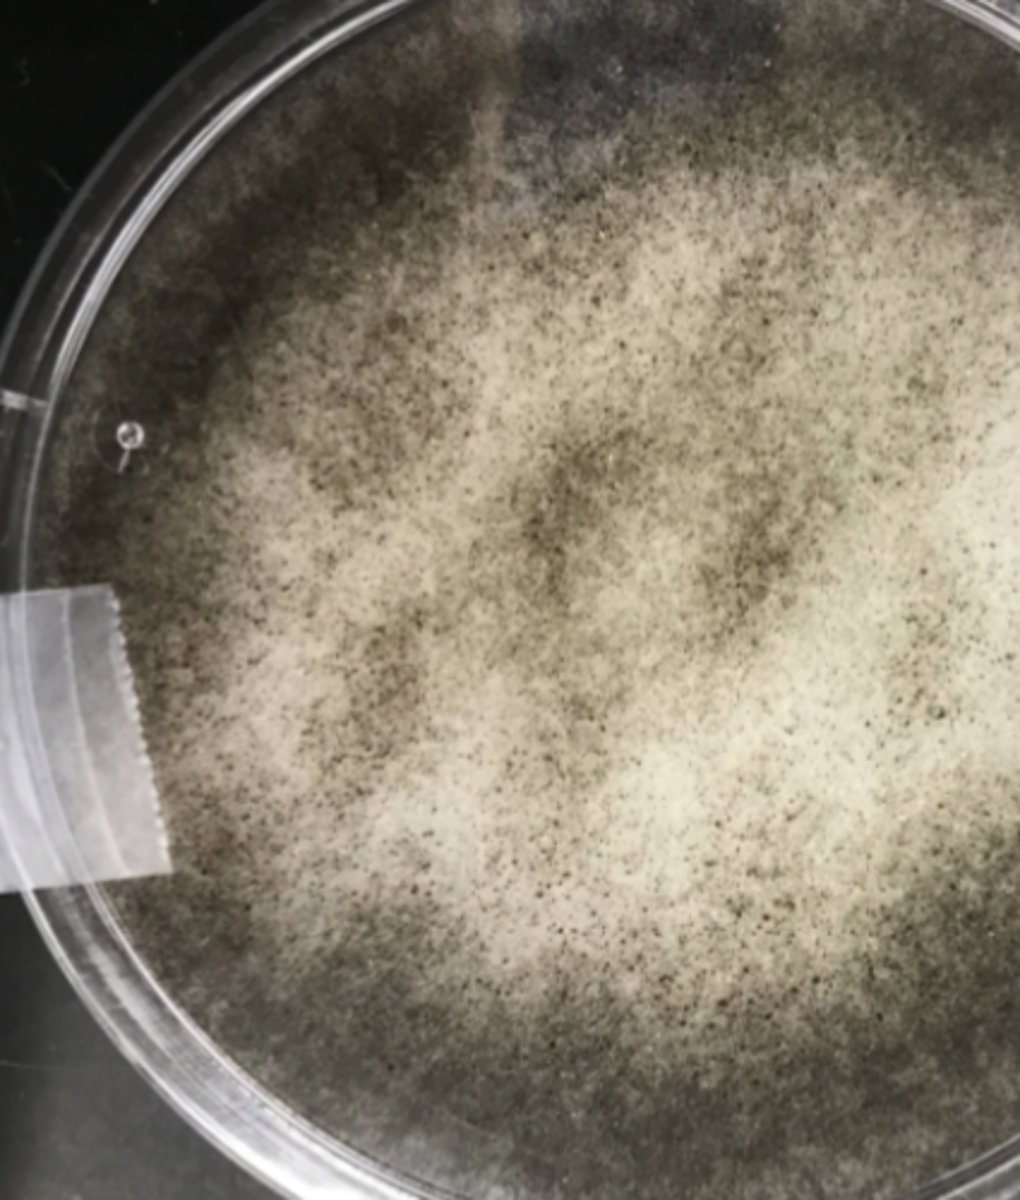
knowt flashcard image
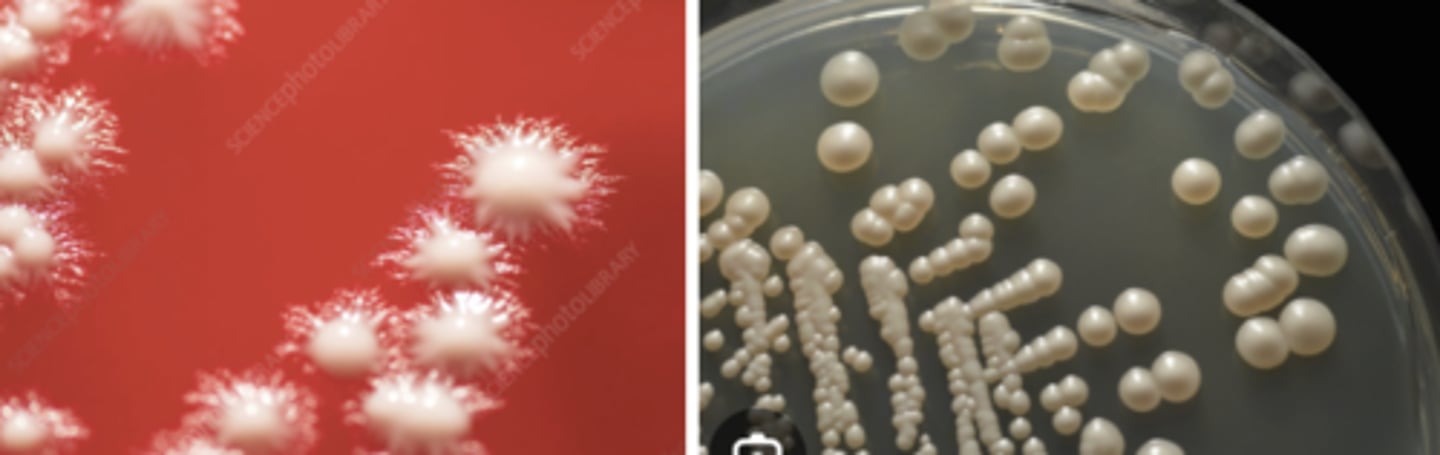
knowt flashcard image
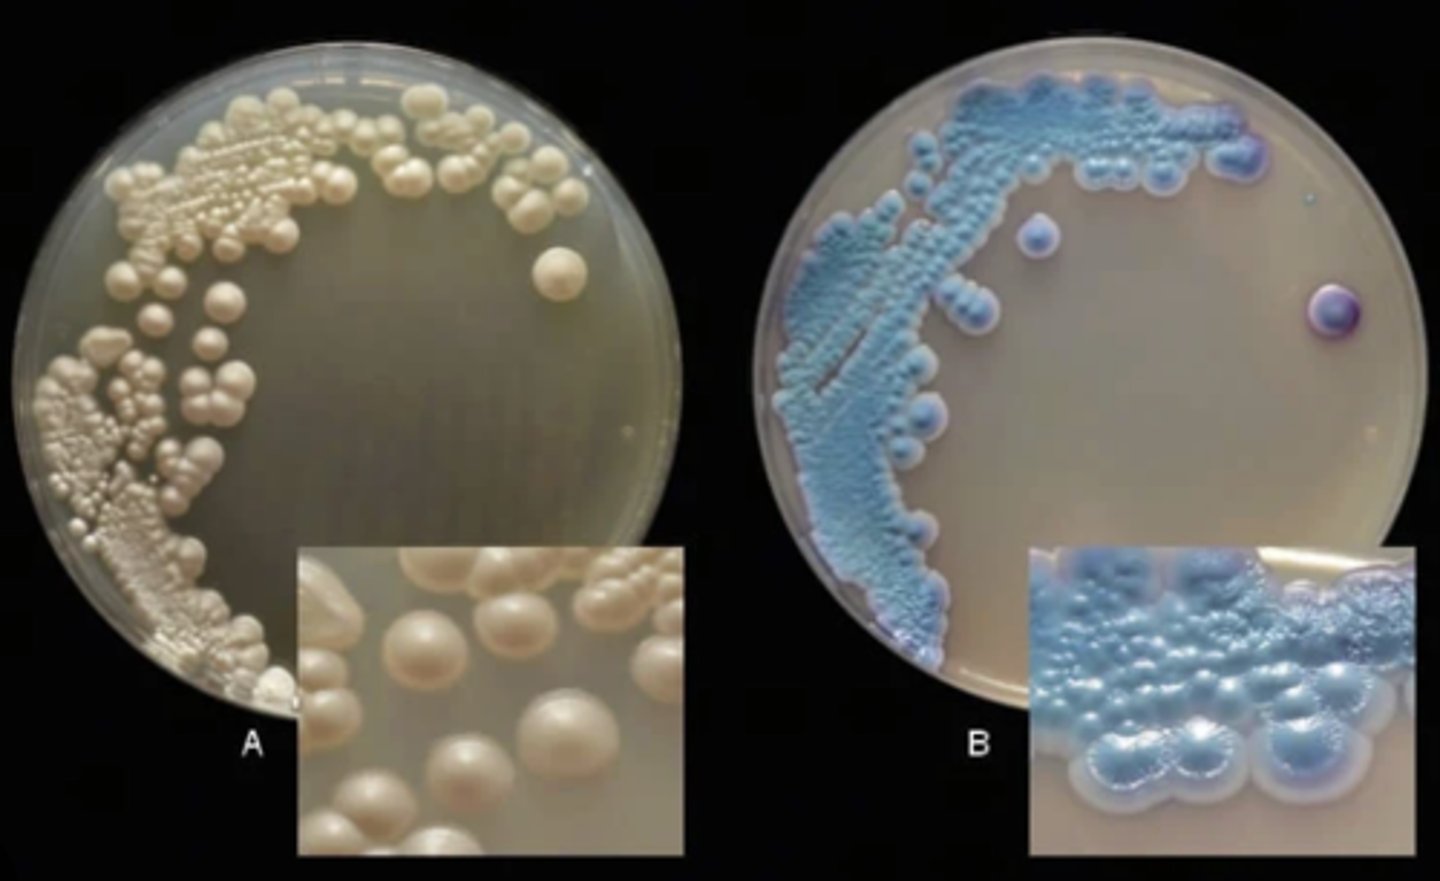
knowt flashcard image
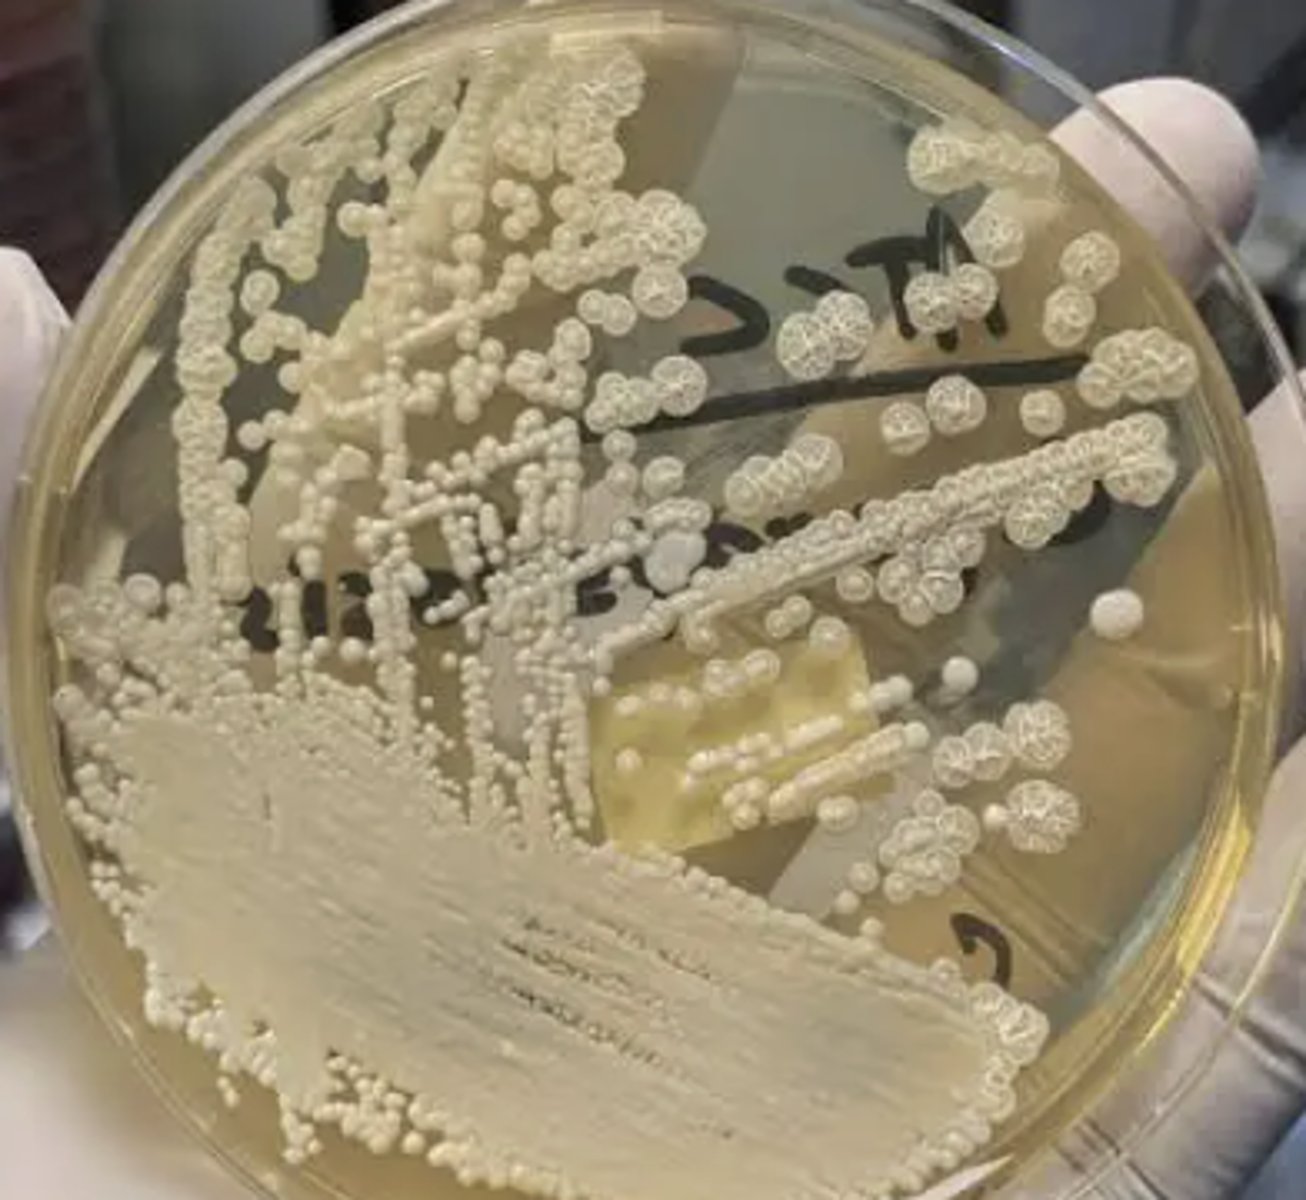
knowt flashcard image
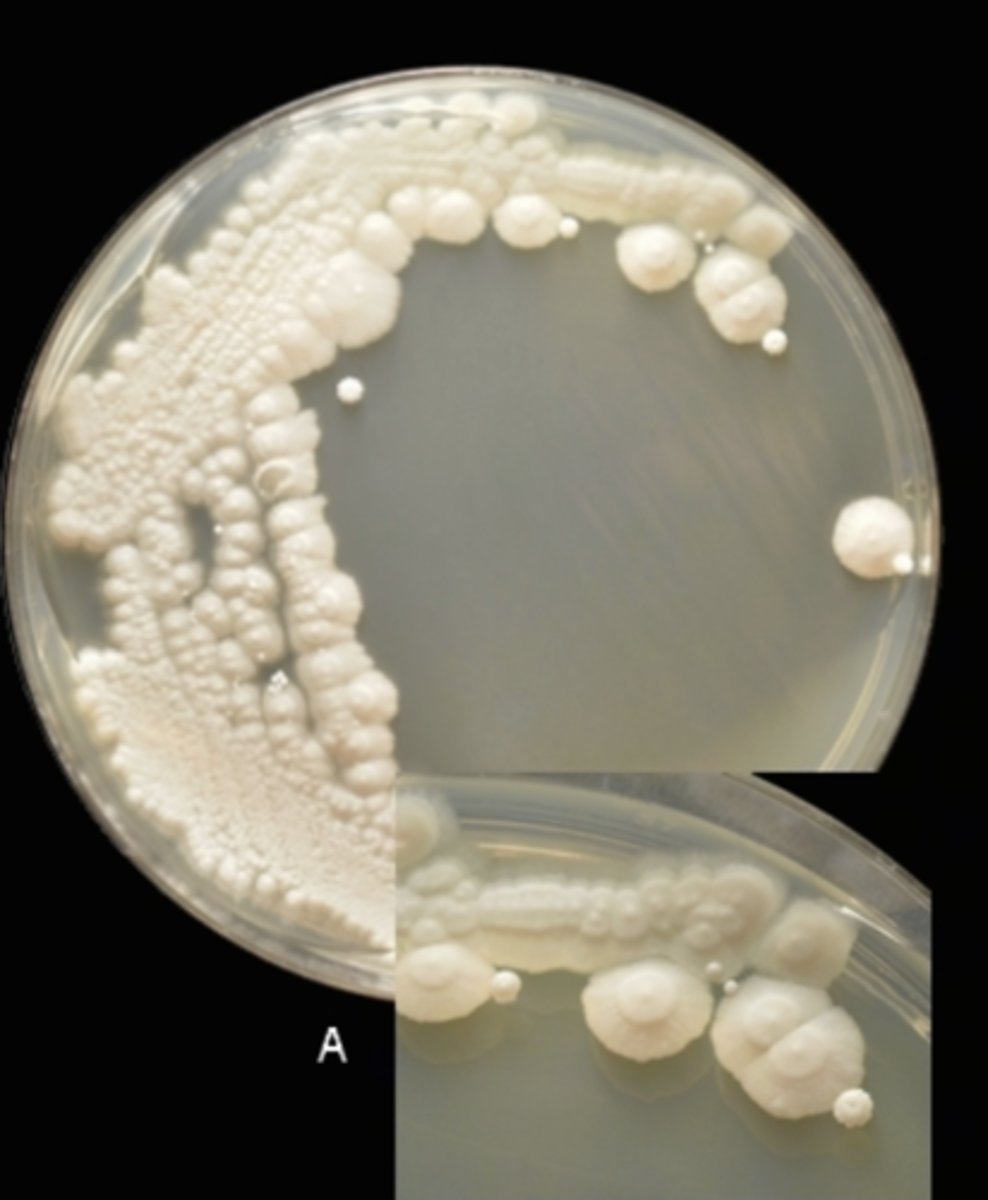
knowt flashcard image

Morphology of yeast and fungus
0.0(0)
0.0(0)
Card Sorting
1/38
There's no tags or description
Looks like no tags are added yet.
Study Analytics
Name | Mastery | Learn | Test | Matching | Spaced | Call with Kai |
|---|
No study sessions yet.
39 Terms
1
New cards
Aspergillus fumigatus

2
New cards
Aspergillus fumigatus front
3
New cards
Aspergillus flavus front
4
New cards
Aspergillus flavus

5
New cards
Aspergillus niger

6
New cards
Aspergillus niger front
7
New cards
Penicillium

8
New cards
Penicillium front

9
New cards
Paecilomyces

10
New cards
Paecilomyces front
11
New cards
Scopulariopsis

12
New cards
Fusarium

13
New cards
Fusarium front
14
New cards
Chrysosporium

15
New cards
Chrysosporium front

16
New cards
Ulocladium

17
New cards
Ulocladium front
18
New cards
Curvularia

19
New cards
Curvularia front
20
New cards
Epicoccum

21
New cards
Epicoccum front
22
New cards
Alternaria

23
New cards
Alternaria front

24
New cards
Rhizopus

25
New cards
Rhizopus front
26
New cards
Mucormycetes book image

27
New cards
Cunninghamella

28
New cards
Cunninghamella front

29
New cards
Mucor

30
New cards
Mucor front
31
New cards
Candida albicans

32
New cards
Candida albicans front
33
New cards
Candida dublineinsis

34
New cards
Candida tropicalis front
35
New cards
Candida tropicalis

36
New cards
Candida parapsilosis front
37
New cards
Candida parapsilosis
38
New cards
Candida krusei
39
New cards
Candida keyfr
